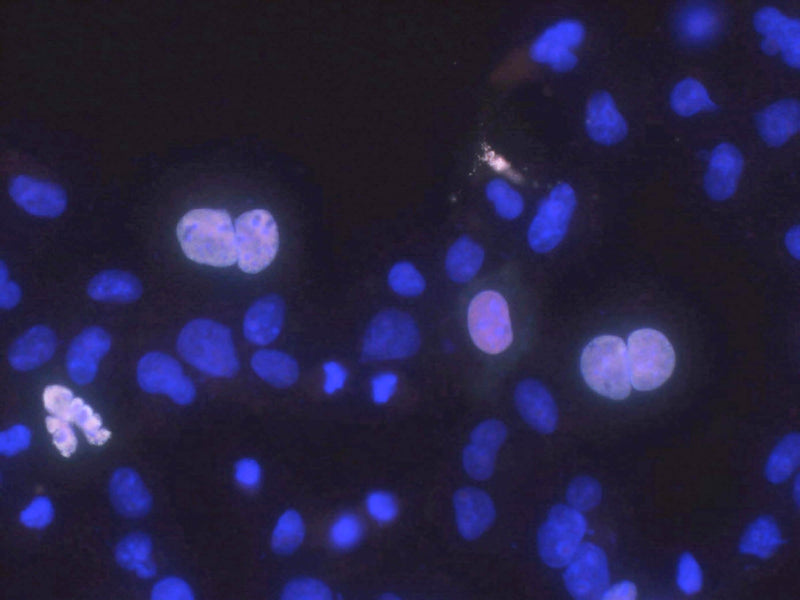

Anti-Haspin/GSG2 Antibody (N128A/2)
Our Anti-Haspin/GSG2 mouse monoclonal primary antibody from NeuroMab is produced in-house from hybridoma clone N128A/2. It detects human Haspin/GSG2, and is purified by Protein A chromatography. It is great for use in ICC, IP, WB.
SKU: 75-161
Ships: 1-2 business days
Product Details
Haspin/GSG2
Histone H3 Associated Protein Kinase is encoded by the gene HASPIN. HASPIN is a member of the protein kinase superfamily, Ser/Thr protein kinase family, and the Haspin subfamily. HASPIN is a serine/threonine - protein kinase that phosphorylates histone H3 at 'Thr-3' (H3T3ph) during mitosis. HASPIN may act through H3T3ph to both position and modulate activation of AURKB and other components of the chromosomal passenger complex (CPC) at centromeres to ensure proper chromatid cohesion, metaphase alignment, and normal progression through the cell cycle. HASPIN is expressed in the testis, thymus, bone marrow, prostate, intestine, lung, spleen, and lymph node. No diseases were found to be associated with HASPIN.
Purified by Protein A chromatography
1 mg/mL
Monoclonal
N128A/2
IgG1
ELISA, ICC, IP, WB
Mouse
HASPIN GSG2
90 kDa
Fusion protein amino acids 1-798 (full-length) of human Haspin (accession number Q8TF76)
Human
Human
AB_2114890
Aliquot and store at ≤ -20°C for long term storage. For short term storage, store at 2-8°C. For maximum recovery of product, centrifuge the vial prior to removing the cap.
Liquid
Produced by in vitro bioreactor culture of hybridoma line followed by Protein A affinity chromatography. Purified mAbs are >90% specific antibody.
10 mM Tris, 50 mM Sodium Chloride, 0.065% Sodium Azide pH 7.87
Unconjugated
No cross-reactivity reported
Each new lot of antibody is quality control tested on cells overexpressing target protein and confirmed to give the expected staining pattern.
These antibodies are to be used as research laboratory reagents and are not for use as diagnostic or therapeutic reagents in humans.
United States
24 months from date of receipt
Serine/threonine-protein kinase haspin (EC 2.7.11.1) (Germ cell-specific gene 2 protein) (H-haspin) (Haploid germ cell-specific nuclear protein kinase)
Shipped on ice packs